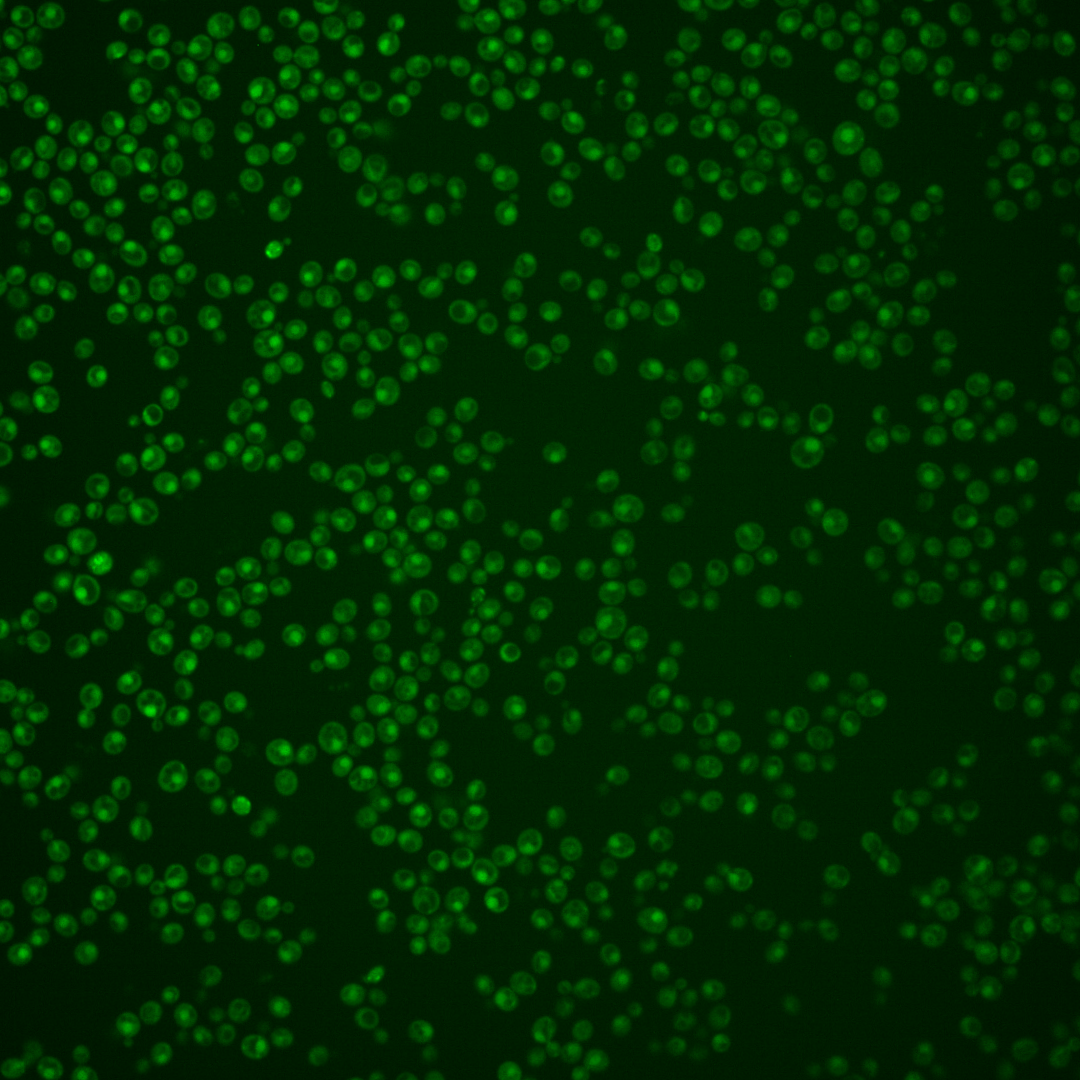
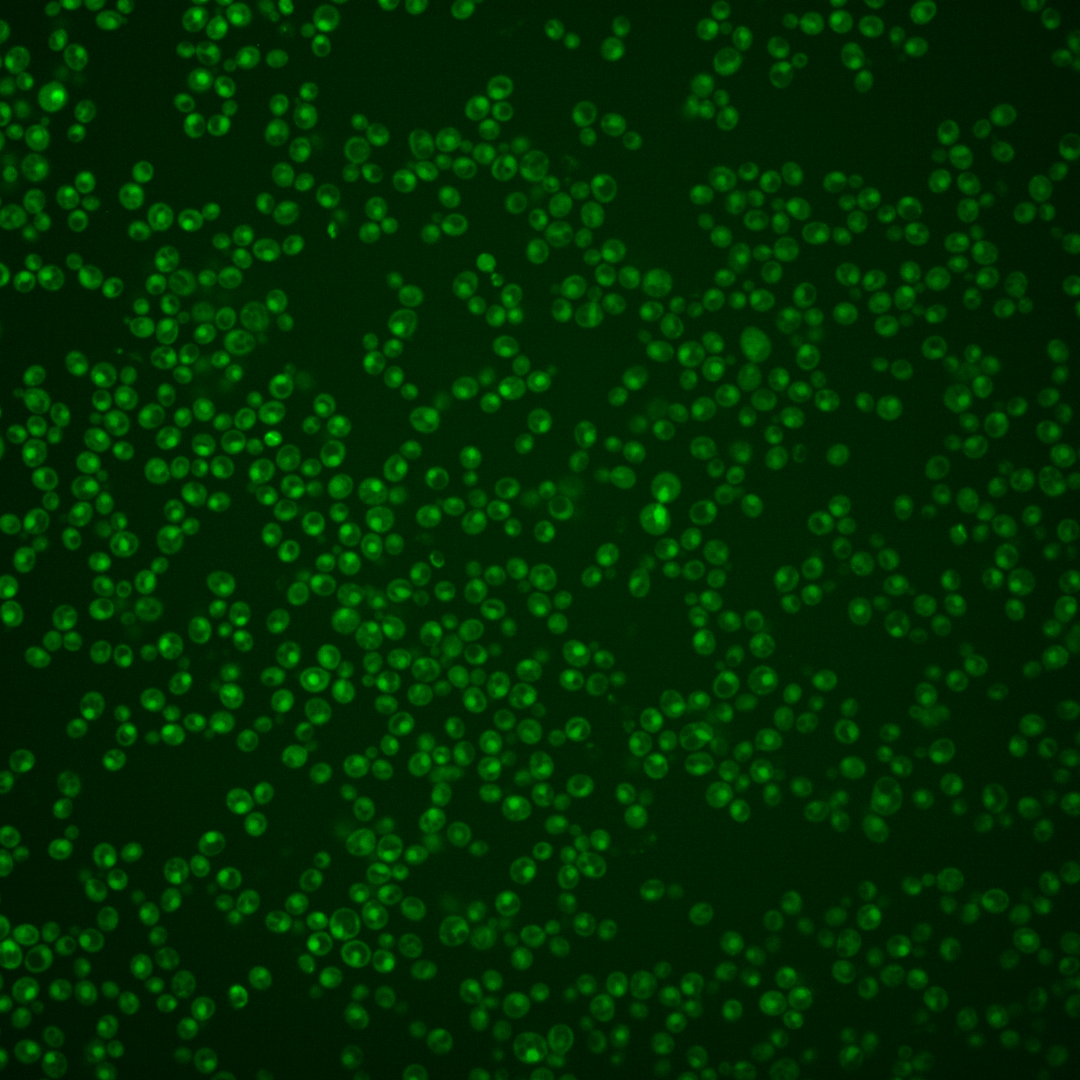
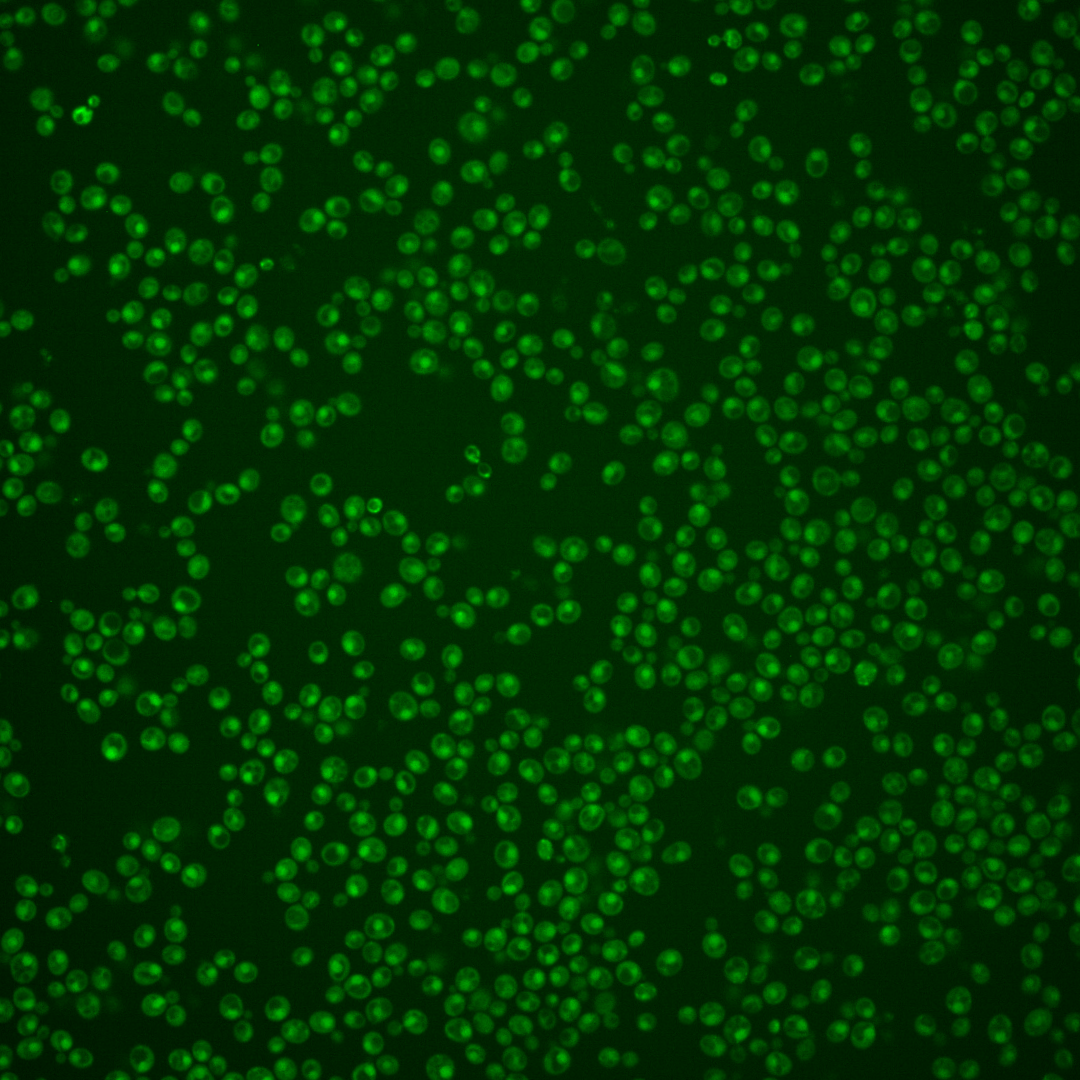
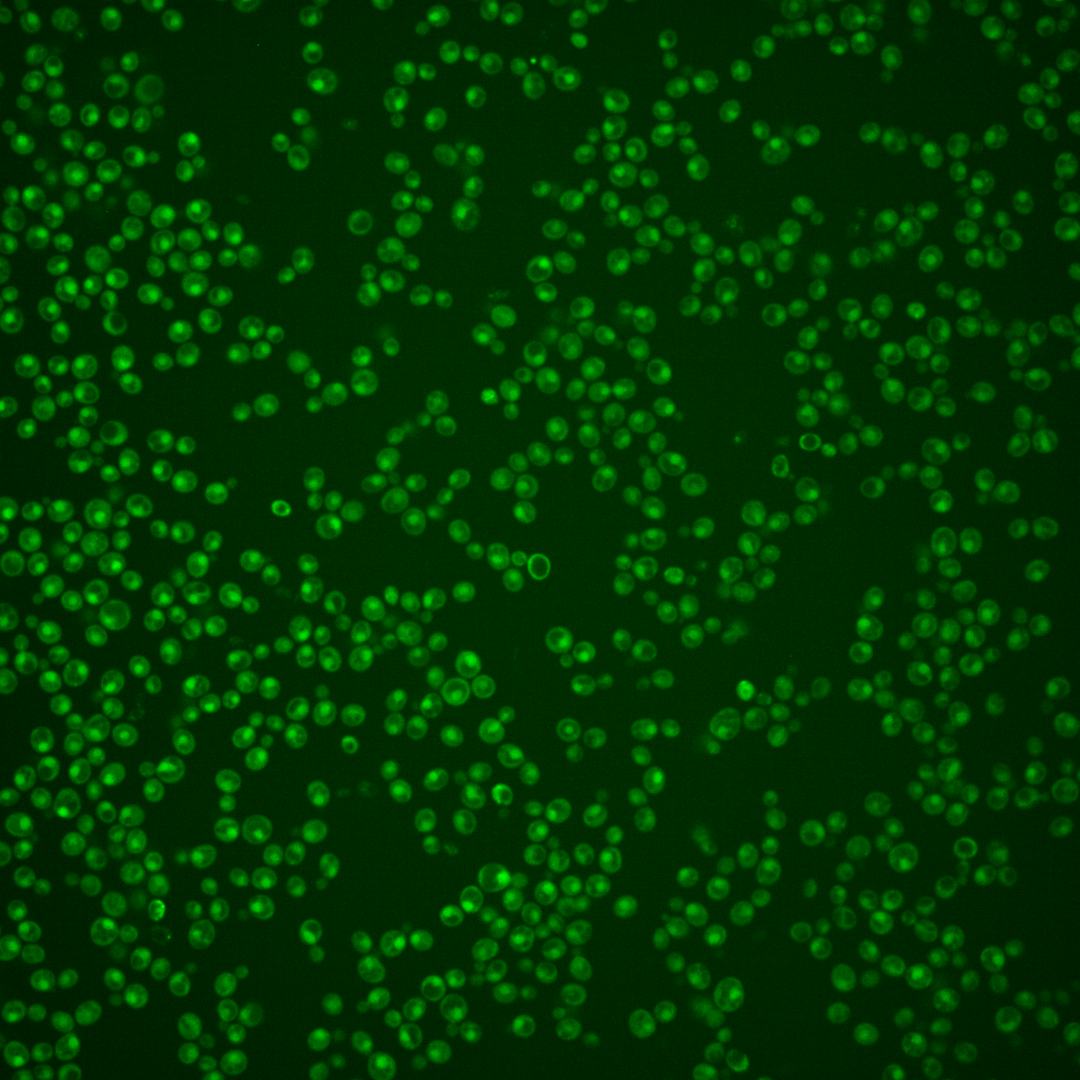
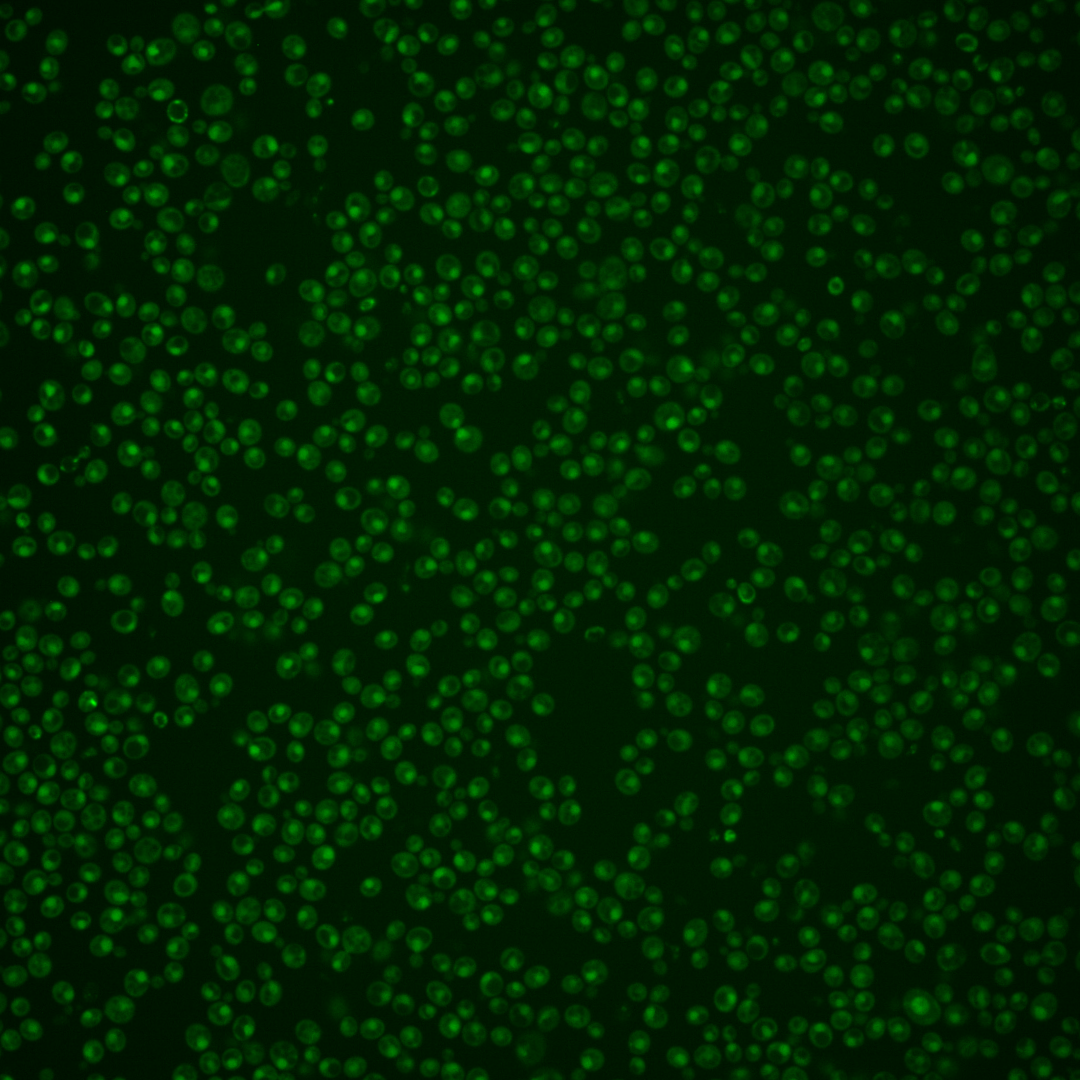

| Standard name | |
|---|---|
| Human Ortholog | |
| Description | Protein that stimulates strand exchange; stimulates strand exchange by stabilizing the binding of Rad51p to single-stranded DNA; involved in the recombinational repair of double-strand breaks in DNA during vegetative growth and meiosis; forms heterodimer with Rad57p |
Micrographs




















































































Sub-cellular Localization
Yeast GFP Assignment
Protein Abundance
Localization Change
External localization resources
| ensLOC | DeepLoc | |||||||||||||||||||||||
|---|---|---|---|---|---|---|---|---|---|---|---|---|---|---|---|---|---|---|---|---|---|---|---|---|
| Localization | WT1 | WT2 | WT3 | RAP60 | RAP140 | RAP220 | RAP300 | RAP380 | RAP460 | RAP540 | RAP620 | RAP700 | HU80 | HU120 | HU160 | rpd3Δ_1 | rpd3Δ_2 | rpd3Δ_3 | WT1 | WT2 | WT3 | AF100 | AF140 | AF180 |
| Cortical Patches | 0 | 0 | 0 | 0 | 0 | 0 | 0 | 0 | 0 | 0 | 0 | 0 | 0 | 0 | 0 | 0 | 0 | 0 | 0 | 0 | 0 | 0 | 0 | 0 |
| Bud | 0 | 0 | 1 | 0 | 0 | 4 | 5 | 5 | 7 | 7 | 6 | 1 | 0 | 0 | 0 | 0 | 0 | 0 | 0 | 2 | 3 | 1 | 3 | 5 |
| Bud Neck | 0 | 0 | 0 | 0 | 0 | 0 | 0 | 1 | 1 | 1 | 0 | 0 | 0 | 0 | 0 | 0 | 0 | 0 | 0 | 1 | 0 | 0 | 1 | 5 |
| Bud Site | 0 | 0 | 0 | 0 | 0 | 1 | 8 | 6 | 9 | 14 | 17 | 4 | 0 | 0 | 0 | 0 | 0 | 0 | – | – | – | – | – | – |
| Cell Periphery | 0 | 0 | 0 | 0 | 0 | 0 | 0 | 0 | 0 | 0 | 0 | 0 | 0 | 0 | 1 | 0 | 0 | 0 | 0 | 0 | 0 | 0 | 0 | 0 |
| Cytoplasm | 4 | 27 | 16 | 19 | 44 | 46 | 44 | 55 | 27 | 28 | 41 | 52 | 20 | 45 | 51 | 12 | 22 | 16 | 2 | 19 | 8 | 12 | 18 | 15 |
| Endoplasmic Reticulum | 0 | 1 | 0 | 1 | 0 | 0 | 1 | 0 | 1 | 0 | 0 | 1 | 2 | 0 | 1 | 7 | 7 | 6 | 0 | 0 | 1 | 0 | 1 | 1 |
| Endosome | 0 | 3 | 4 | 0 | 17 | 2 | 1 | 0 | 2 | 3 | 1 | 5 | 0 | 1 | 1 | 0 | 2 | 0 | 0 | 5 | 1 | 0 | 4 | 1 |
| Golgi | 0 | 0 | 1 | 0 | 0 | 0 | 0 | 0 | 0 | 0 | 0 | 0 | 0 | 0 | 0 | 0 | 1 | 2 | 1 | 1 | 1 | 1 | 0 | 0 |
| Mitochondria | 7 | 56 | 24 | 24 | 23 | 225 | 266 | 351 | 214 | 248 | 306 | 281 | 3 | 0 | 0 | 5 | 9 | 1 | 2 | 10 | 2 | 6 | 5 | 8 |
| Nucleus | 31 | 220 | 133 | 155 | 172 | 194 | 188 | 280 | 132 | 159 | 176 | 153 | 88 | 144 | 116 | 62 | 94 | 80 | 58 | 234 | 144 | 76 | 174 | 125 |
| Nuclear Periphery | 0 | 0 | 0 | 2 | 0 | 1 | 2 | 5 | 0 | 0 | 2 | 2 | 0 | 0 | 0 | 0 | 0 | 0 | 0 | 0 | 0 | 0 | 0 | 0 |
| Nucleolus | 1 | 0 | 0 | 0 | 0 | 3 | 3 | 3 | 1 | 2 | 0 | 0 | 0 | 0 | 0 | 0 | 0 | 0 | 0 | 0 | 0 | 0 | 3 | 4 |
| Peroxisomes | 0 | 0 | 0 | 0 | 1 | 0 | 0 | 0 | 0 | 0 | 0 | 0 | 0 | 0 | 0 | 0 | 0 | 0 | 0 | 0 | 0 | 0 | 0 | 0 |
| SpindlePole | 0 | 1 | 0 | 0 | 2 | 2 | 1 | 0 | 1 | 0 | 1 | 1 | 0 | 1 | 0 | 0 | 1 | 0 | 1 | 7 | 0 | 4 | 10 | 8 |
| Vac/Vac Membrane | 7 | 29 | 27 | 19 | 51 | 42 | 30 | 37 | 47 | 37 | 38 | 71 | 10 | 12 | 20 | 21 | 14 | 26 | 2 | 48 | 33 | 36 | 95 | 79 |
| Unique Cell Count | 38 | 298 | 184 | 200 | 271 | 381 | 395 | 535 | 301 | 366 | 407 | 411 | 116 | 194 | 176 | 91 | 131 | 114 | 71 | 339 | 201 | 145 | 324 | 266 |
| Labelled Cell Count | 50 | 337 | 206 | 220 | 310 | 520 | 549 | 743 | 442 | 499 | 588 | 571 | 123 | 203 | 190 | 107 | 150 | 131 | 71 | 339 | 201 | 145 | 324 | 266 |
Yeast GFP Assignment
Protein Abundance
| Screen | WT1 | WT2 | WT3 | RAP60 | RAP140 | RAP220 | RAP300 | RAP380 | RAP460 | RAP540 | RAP620 | RAP700 | HU80 | HU120 | HU160 | rpd3Δ_1 | rpd3Δ_2 | rpd3Δ_3 | AF100 | AF140 | AF180 |
|---|---|---|---|---|---|---|---|---|---|---|---|---|---|---|---|---|---|---|---|---|---|
| Mean Cell GFP Intensity (1e-4) | 4.6 | 4.6 | 4.6 | 4.7 | 5.3 | 3.7 | 3.7 | 3.9 | 3.5 | 3.7 | 3.5 | 3.5 | 5.3 | 5.4 | 5.6 | 6.4 | 6.4 | 6.5 | 4.8 | 5.1 | 5.2 |
| Std Deviation (1e-4) | 0.5 | 0.9 | 0.9 | 1.8 | 4.2 | 1.8 | 2.1 | 1.1 | 0.6 | 1.1 | 1.0 | 1.1 | 1.1 | 1.0 | 1.1 | 1.1 | 1.2 | 1.3 | 0.8 | 1.1 | 1.0 |
| Intensity Change (Log2) | – | – | – | 0.05 | 0.22 | -0.3 | -0.29 | -0.24 | -0.4 | -0.31 | -0.39 | -0.38 | 0.22 | 0.23 | 0.29 | 0.49 | 0.49 | 0.5 | 0.07 | 0.15 | 0.2 |
Localization Change
| Localization | RAP60 | RAP140 | RAP220 | RAP300 | RAP380 | RAP460 | RAP540 | RAP620 | RAP700 | HU80 | HU120 | HU160 | rpd3Δ_1 | rpd3Δ_2 | rpd3Δ_3 |
|---|---|---|---|---|---|---|---|---|---|---|---|---|---|---|---|
| Actin | – | – | – | – | – | – | – | – | – | – | – | – | – | – | – |
| Bud | – | – | – | – | – | – | – | – | – | – | – | – | 0 | 0 | 0 |
| Bud Neck | – | – | – | – | – | – | – | – | – | – | – | – | 0 | 0 | 0 |
| Bud Site | – | – | – | – | – | – | – | – | – | – | – | – | 0 | 0 | 0 |
| Cell Periphery | – | – | – | – | – | – | – | – | – | – | – | – | 0 | 0 | 0 |
| Cyto | – | – | – | – | – | – | – | – | – | – | – | – | – | – | – |
| Endoplasmic Reticulum | – | – | – | – | – | – | – | – | – | – | – | – | 0 | 0 | 0 |
| Endosome | – | – | – | – | – | – | – | – | – | – | – | – | 0 | 0 | 0 |
| Golgi | – | – | – | – | – | – | – | – | – | – | – | – | 0 | 0 | 0 |
| Mitochondria | – | – | – | – | – | – | – | – | – | – | – | – | 0 | 0 | 0 |
| Nuclear Periphery | – | – | – | – | – | – | – | – | – | – | – | – | 0 | 0 | 0 |
| Nuc | – | – | – | – | – | – | – | – | – | – | – | – | – | – | – |
| Nucleolus | – | – | – | – | – | – | – | – | – | – | – | – | 0 | 0 | 0 |
| Peroxisomes | – | – | – | – | – | – | – | – | – | – | – | – | 0 | 0 | 0 |
| SpindlePole | – | – | – | – | – | – | – | – | – | – | – | – | 0 | 0 | 0 |
| Vac | – | – | – | – | – | – | – | – | – | – | – | – | – | – | – |
| Cortical Patches | – | – | – | – | – | – | – | – | – | – | – | – | 0 | 0 | 0 |
| Cytoplasm | – | – | – | – | – | – | – | – | – | – | – | – | 0 | 0 | 0 |
| Nucleus | – | – | – | – | – | – | – | – | – | – | – | – | 0 | 0 | 0 |
| Vacuole | – | – | – | – | – | – | – | – | – | – | – | – | 1.7 | -1.0 | 1.8 |
External localization resources
Images






























Protein Concentration and Protein Localization Data
| R1 | R2 | R3 | ||||||||||||||||
|---|---|---|---|---|---|---|---|---|---|---|---|---|---|---|---|---|---|---|
| G1 Pre-START | G1 Post-START | S/G2 | Metaphase | Anaphase | Telophase | G1 Pre-START | G1 Post-START | S/G2 | Metaphase | Anaphase | Telophase | G1 Pre-START | G1 Post-START | S/G2 | Metaphase | Anaphase | Telophase | |
| Concentration | -0.6946 | -0.4683 | -0.3496 | -0.421 | -0.8979 | -0.3496 | 0.9193 | 1.367 | 1.2724 | 1.0793 | 0.9761 | 1.1613 | -0.6606 | 0.0997 | -0.5378 | -0.2891 | -0.5357 | -0.0934 |
| Actin | 0.0109 | 0.0004 | 0.0071 | 0.0005 | 0.0259 | 0.0071 | 0.0191 | 0.0001 | 0.0032 | 0.0079 | 0.0001 | 0.0004 | 0.0035 | 0.0005 | 0 | 0.0003 | 0.0015 | 0.0001 |
| Bud | 0.0002 | 0.0002 | 0.0004 | 0.0001 | 0.0003 | 0.0002 | 0.0005 | 0.0001 | 0.0005 | 0.0012 | 0.0003 | 0.0001 | 0.0016 | 0.0001 | 0 | 0.0001 | 0 | 0.0001 |
| Bud Neck | 0.0009 | 0.0004 | 0.0007 | 0.0007 | 0.0007 | 0.0015 | 0.0022 | 0.0003 | 0.0011 | 0.0003 | 0.0011 | 0.0011 | 0.0027 | 0.0006 | 0.0001 | 0.0003 | 0.0004 | 0.0015 |
| Bud Periphery | 0.0005 | 0.0002 | 0.0004 | 0.0001 | 0.0003 | 0.0004 | 0.0005 | 0 | 0.0012 | 0.0008 | 0.0001 | 0.0001 | 0.0096 | 0.0001 | 0 | 0.0001 | 0 | 0.0001 |
| Bud Site | 0.0008 | 0.0018 | 0.0042 | 0.0015 | 0.0023 | 0.0004 | 0.0074 | 0.0006 | 0.0027 | 0.0014 | 0.0028 | 0.0001 | 0.0029 | 0.0032 | 0.0001 | 0.0002 | 0.0002 | 0.0001 |
| Cell Periphery | 0.0001 | 0.0001 | 0.0001 | 0 | 0 | 0.0001 | 0.0003 | 0 | 0.0003 | 0 | 0 | 0 | 0.0035 | 0.0001 | 0 | 0 | 0 | 0 |
| Cytoplasm | 0.053 | 0.0305 | 0.0236 | 0.0159 | 0.0352 | 0.0211 | 0.0427 | 0.0352 | 0.0159 | 0.0117 | 0.0128 | 0.0142 | 0.021 | 0.0723 | 0.007 | 0.041 | 0.0479 | 0.0347 |
| Cytoplasmic Foci | 0.0133 | 0.001 | 0.0071 | 0.0238 | 0.0055 | 0.0012 | 0.0223 | 0.0005 | 0.0055 | 0.0029 | 0.0396 | 0.0004 | 0.025 | 0.0017 | 0.0003 | 0.0009 | 0.0087 | 0.0003 |
| Eisosomes | 0.0002 | 0 | 0.0002 | 0 | 0.0002 | 0.0001 | 0.0008 | 0 | 0.0001 | 0.0001 | 0 | 0 | 0.0001 | 0 | 0 | 0 | 0 | 0 |
| Endoplasmic Reticulum | 0.0029 | 0.0015 | 0.0011 | 0.0006 | 0.0009 | 0.0012 | 0.0032 | 0.0008 | 0.0009 | 0.0009 | 0.0002 | 0.0034 | 0.0009 | 0.0027 | 0.0001 | 0.0022 | 0.0011 | 0.0004 |
| Endosome | 0.0089 | 0.0022 | 0.0052 | 0.002 | 0.0019 | 0.006 | 0.0175 | 0.0008 | 0.0121 | 0.0046 | 0.0151 | 0.0018 | 0.0032 | 0.0024 | 0.0002 | 0.0019 | 0.0056 | 0.0004 |
| Golgi | 0.0031 | 0.0001 | 0.0013 | 0.0007 | 0.0026 | 0.0031 | 0.0149 | 0 | 0.0025 | 0.0014 | 0.0026 | 0.0006 | 0.0013 | 0.0001 | 0 | 0 | 0.0122 | 0 |
| Lipid Particles | 0.0092 | 0.0003 | 0.0042 | 0.0067 | 0.0044 | 0.0021 | 0.0136 | 0 | 0.009 | 0.0065 | 0.0012 | 0.0056 | 0.0052 | 0.0002 | 0 | 0.0001 | 0.1 | 0 |
| Mitochondria | 0.0017 | 0.0013 | 0.0027 | 0.0007 | 0.003 | 0.0073 | 0.0093 | 0.0004 | 0.0075 | 0.0065 | 0.0005 | 0.0028 | 0.0107 | 0.0005 | 0.0002 | 0.0006 | 0.0024 | 0.0003 |
| None | 0.0673 | 0.0629 | 0.0705 | 0.0243 | 0.0142 | 0.0638 | 0.0415 | 0.0187 | 0.0357 | 0.01 | 0.0036 | 0.0016 | 0.056 | 0.124 | 0.0771 | 0.006 | 0.1049 | 0.0108 |
| Nuclear Periphery | 0.0266 | 0.0243 | 0.0313 | 0.0301 | 0.0128 | 0.0126 | 0.0116 | 0.0181 | 0.0071 | 0.0106 | 0.0046 | 0.0097 | 0.0125 | 0.0179 | 0.0032 | 0.0378 | 0.0087 | 0.0032 |
| Nucleolus | 0.004 | 0.0049 | 0.0038 | 0.0064 | 0.0085 | 0.0085 | 0.0036 | 0.0037 | 0.0045 | 0.003 | 0.007 | 0.0065 | 0.0041 | 0.0053 | 0.0024 | 0.0026 | 0.0043 | 0.0042 |
| Nucleus | 0.7633 | 0.8527 | 0.8123 | 0.8263 | 0.8424 | 0.8442 | 0.7528 | 0.901 | 0.8537 | 0.9003 | 0.8843 | 0.9416 | 0.8007 | 0.7072 | 0.9074 | 0.8859 | 0.666 | 0.9355 |
| Peroxisomes | 0.0044 | 0.0004 | 0.0025 | 0.0022 | 0.0091 | 0.0006 | 0.0133 | 0.0001 | 0.0113 | 0.0178 | 0.0045 | 0.0005 | 0.0119 | 0.0001 | 0 | 0 | 0.0139 | 0 |
| Punctate Nuclear | 0.0243 | 0.013 | 0.0199 | 0.0563 | 0.0291 | 0.0165 | 0.0208 | 0.0188 | 0.0164 | 0.0095 | 0.0183 | 0.009 | 0.0095 | 0.059 | 0.0015 | 0.0188 | 0.021 | 0.0078 |
| Vacuole | 0.0032 | 0.0015 | 0.0011 | 0.0005 | 0.0007 | 0.0013 | 0.0017 | 0.0006 | 0.0073 | 0.0013 | 0.0011 | 0.0004 | 0.0105 | 0.0018 | 0.0002 | 0.0007 | 0.0006 | 0.0004 |
| Vacuole Periphery | 0.0012 | 0.0005 | 0.0004 | 0.0003 | 0.0003 | 0.0009 | 0.0005 | 0.0002 | 0.0015 | 0.0009 | 0.0001 | 0.0003 | 0.0034 | 0.0003 | 0.0001 | 0.0004 | 0.0002 | 0.0001 |
Sequencing Data
| R1 | R2 | |||||||||
|---|---|---|---|---|---|---|---|---|---|---|
| G1 Post-START | S/G2 | Metaphase | Anaphase | Telophase | G1 Post-START | S/G2 | Metaphase | Anaphase | Telophase | |
| Gene Expression | 9.0369 | 4.8471 | 3.5967 | 5.1555 | 7.03 | 5.4191 | 4.084 | 3.0321 | 4.0288 | 7.5911 |
| Translational Efficiency | 0.501 | 0.7013 | 0.6576 | 0.5329 | 0.4095 | 0.7869 | 0.6179 | 0.6993 | 0.5357 | 0.56 |
Hit Data
| Dataset | Hit |
|---|---|
| Protein Concentration | ✘ |
| Protein Localization | ✘ |
| Gene Expression | ✔ |
| Translational Efficiency | ✘ |
Endocytosis
| Temp | Actin Patch (Sac6-tdTomato) | Cortical Patch (Sla1-GFP) | Late Endosome (Snf7-GFP) | Vacuole (Vph1-GFP) |
|---|---|---|---|---|
| 37℃ | ||||
| RT |
Cell Cycle Omics
CYCLoPs (Rad55-GFP)
| Gene / Allele | Actin Patch (Sac6-tdTomato) | Cortical Patch (Sla1-GFP) | Late Endosome (Snf7-GFP) | Vacuole (Sac6-tdTomato) |
|---|
| Gene | Images |
|---|
| Gene | Images |
|---|
Images are not yet available
Images are not yet available